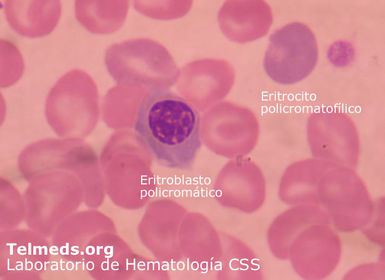
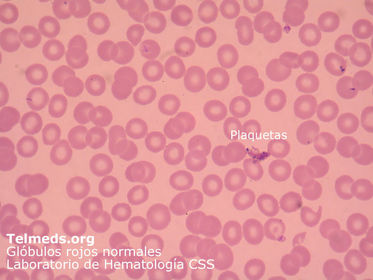
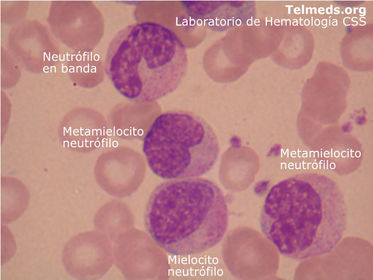
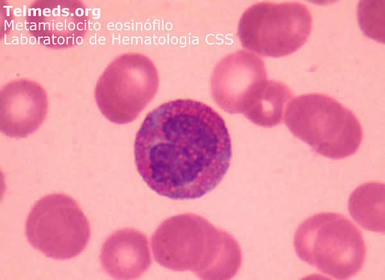
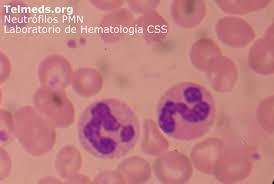
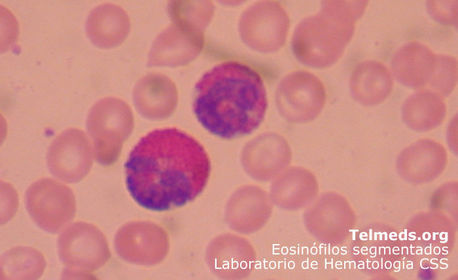
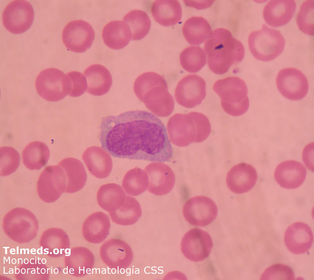
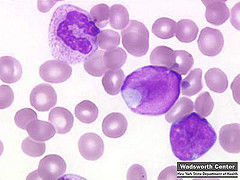
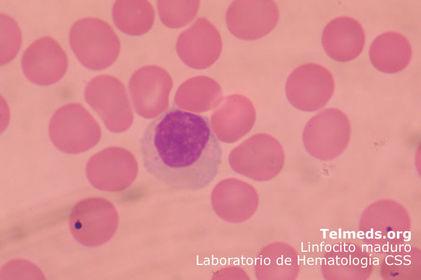
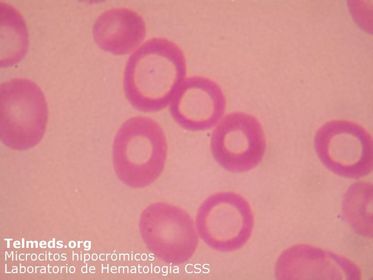
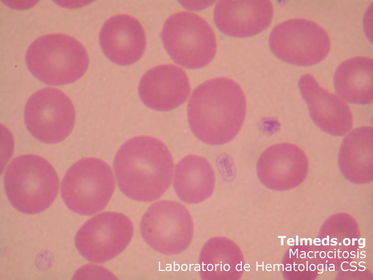
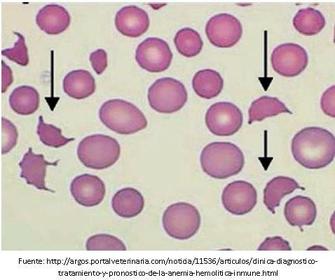

Close

PROERITROBLASTO

ERITROBLASTO BASÓFILO

ERITROBLASTO POLICROMÁTICO
ERITROBLASTO ORTOCROMÁTICO

RETICULOCITO

ERITROCITO
MIELOBLASTO

PROMIELOCITO

MIELOCITO
METAMIELOCITO
BANDA O CAYADO

NEUTRÓFILO
EOSINÓFILO
BASÓFILO

MONOBLASTO

PROMONOCITO

MONOCITO
LINFOBLASTO
PROLINFOCITO

LINFOCITO
MEGACARIOBLASTO

PROMEGACARIOCITO

MEGACARIOCITO

PAQUETAS

ANEMIA NORMOCÍTICA NORMOCRÓMICA

ANEMIA MICROCÍTICA HIPOCRÓMICA
ANEMIA MACROCÍTICA NORMOCRÓMICA
ANEMIA HEMOLÍTICA
LEUCEMIA MIELOIDE AGUDA

LEUCEMIA MIELOIDE CRÓNICA

LEUCEMIA LINFOIDE AGUDA

LEUCEMIA LINFOIDE CRÓNICA

REFERENCIAS
-Ross, M. (2008). Histología: texto y atlas a color con biología celular y molecular. Buenos Aires: Médica panamericana.
- Manascero, A. (2003). Hematología herramienta para el diagnóstico: atlas de morfología celular, alteraciones y enfermedades relacionadas. Colombia: CEJA.
- Rodak, F. (2004). Hematología: Fundamentos y aplicaciones clínicas – 2ª ed. Buenos Aires: Médica panamericana.

 Hide known cards
Hide known cards